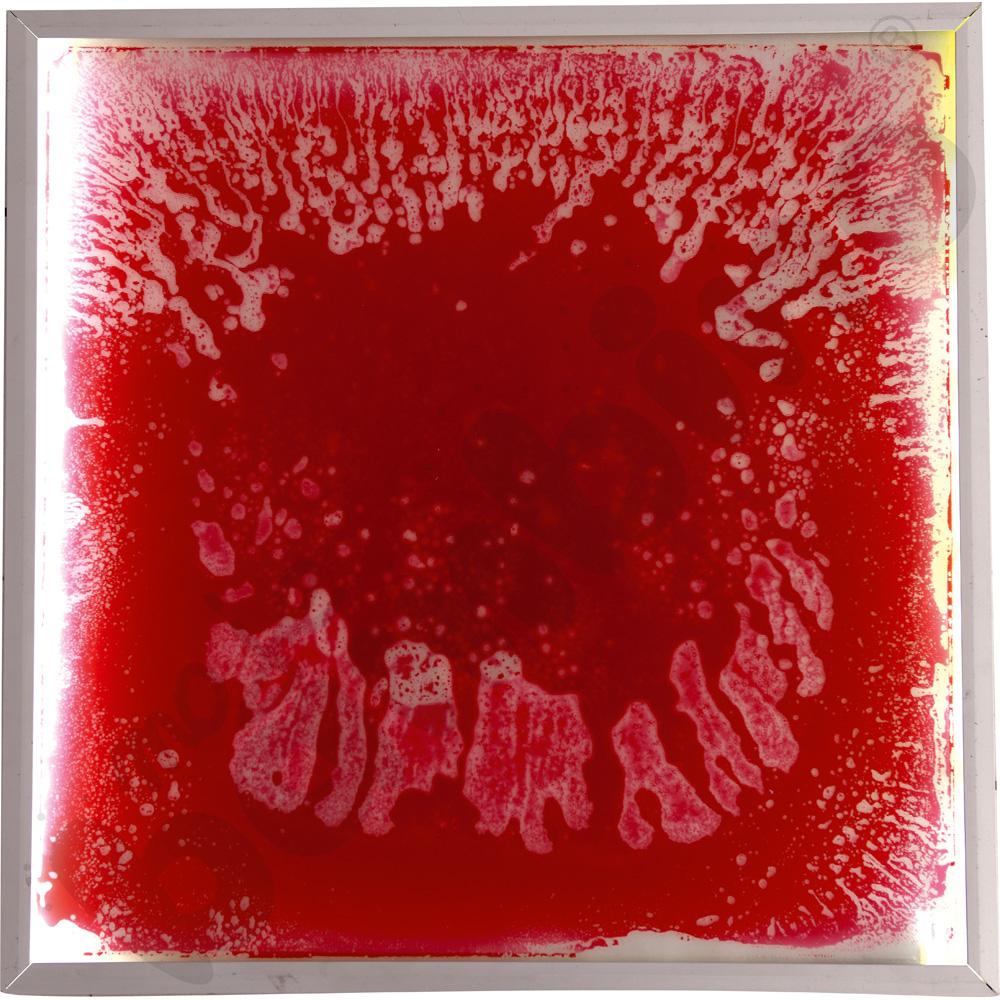
Podświetlany panel podłogowy, czerwony

• czyszczenie: przecierać wilgotną szmatką • aby powierzchnia nie zarysowała się, nie zaleca się chodzenia po płytkach w butach
• wym. 50 x 50 x 5 cm
Przeznaczenie: przedszkole , szkoła I-III , specjalne potrzeby edukacyjne
Wiek: 3-6 lat , 7-9 lat
Producent/Importer/Dostawca
Producent/Importer/Dostawca
ul. Graniczna 46
93-428 Łódź
produkt@mojebambino.pl